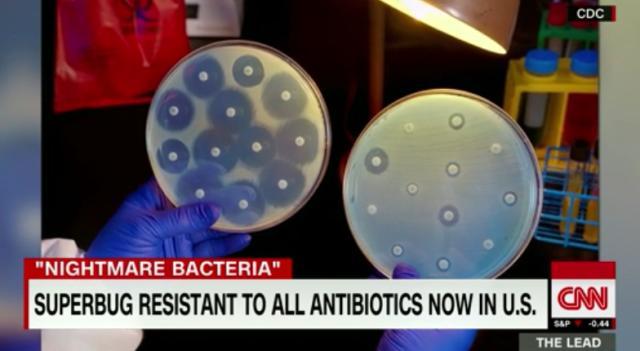
개드립 - 미국에서 모든 항생 물질에 면역인 슈퍼버그 감염자, 처음으로 확인. : 3cd2e52d61c6d18fcd7ca75b2b5ba02f.jpg 1.jpg

미국에서 모든 항생 물질에 면역인 슈퍼버그 감염자, 처음으로 확인.
http://www.nbcnews.com/health/health-news/nightmare-bacteria-superbug-found-first-time-u-s-n581096
미국 질병 대책 센터 CDC 발표에 따르면,
환자는 미국 펜실베니아 주에 사는 49살 여성으로
인류가 만들어낸 모든 형태의 항생 물질에 면역을 갖춘 특수 대장균에 감염됐다고 한다.
현재 격리 중이며, 해당 여성이 대장균에 감염된 경로를 추적 중이다.
이 게시물을
번호
제목
작성자
날짜
조회 수
섬네일
